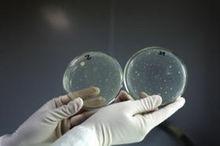
細菌污染指標

定義
 細菌污染指標
細菌污染指標細菌污染指標是從細菌學的角度來指示水源的污染程度。水中微生物大多數為非致病性,只有少數是致病性的。含有病原體的人畜糞便、污水污染水體後,水體中可能含有致病因子。居民常通過飲用、接觸等途徑引起介水傳染病的暴發流行,對人體健康造成危害。最常見的疾病包括霍亂、傷寒、痢疾、甲型病毒性肝炎、隱抱子蟲等腸道傳染病及血吸蟲、賈第蟲病等寄生蟲病。腸道傳染病的傳播主要是由於水中致病性微生物的傳播。為了保證水體的衛生質量,應對不同類型的水質進行微生物的檢測。由於水中致病菌含量少,檢測步驟複雜,耗時長,所以難度較大,因此世界各國一般都是先檢測衛生指示菌,必要時才對各種致病菌逐一檢測。對於水中細菌衛生學所關注的主要是來自人或動物隨糞便排出體外的腸道致病菌和病毒。因此以一種能代表糞便污染的細菌作為有腸道致病菌和病毒危險的細菌污染指標是合乎邏輯的,在方法上也比較切實可行 。
糞便污染指示菌的條件
作為細菌污染指標的理想的指示菌應具備以下條件:
1.在污染的水中有致病菌存在,指示菌亦應存在。
2.不存在於未污染水中。
3.指示菌在數量上應大於致病菌數量。
4.指示菌的密度與污染程度有一定的相關。
5.在水中生存壽命要比致病菌長,並對消毒劑有相同或較強的抵抗力。
6.作為微生物指標,應適用於各種水源。
7.指示菌的特性應是穩定的,在水中不能繁殖。
8.檢測方法簡便、快速、定量、準確性高。
國際通用指標
(1)菌落總數
細菌污染指標
細菌污染指標菌落總數作為判斷水質被污染程度的標誌之一,所測得菌落總數增多,說明水被微生物污染,但不能說明污染的來源。必須結合糞便污染指示菌來判斷水污染的來源和安全程度 。
(2)總大腸菌群
總大腸菌群是腸道中最普遍、數量最多的一類細菌,可在人和溫血動物糞便中檢出,少數菌種可在外環境檢出。具有較強的抗逆性,而且在水中的數量與腸道致病菌呈一定的相關性。在35℃、48h內發酵乳糖產酸產氣的、需氧及兼性厭氧的、革蘭氏陰性的無芽抱桿菌,主要由以下四個菌屬組成:埃希菌屬、克雷伯菌屬、腸桿菌屬和構椽酸桿菌屬。由於大腸埃希菌的鑑定方法比較複雜,1973年H.E約旦(JordonH.E)提議在衛生細菌學上用TC代替E.coli。這一建議受到了各國學者的重視,便逐步以TC代替E.coli作為食品和水質被糞便污染的指示菌。2006年《生活飲用水衛生標準》中增加了總大腸菌群的新定義,即總大腸菌群是指用孔徑為0.45pm的微孔濾膜過濾水樣,將濾膜貼在選擇性培養基上,能產生β一半乳糖苷酶分解ONPG使菌落呈黃色的細菌群組為本方法定義的總大腸菌群。根據這個定義,總大腸菌群的檢測時間縮短到了18一24小時 。
(3)糞大腸菌群
糞大腸菌群與總大腸菌群相似,只是需要將培養溫度提高到44.5℃,仍能發酵乳糖產酸產氣的總大腸菌群微生物。其數量直接表明了水體受糞便污染的程度,是國際上通行的監測水質受糞便污染的指示菌,適用於河流、湖泊、廢水處理系統、野外浴場用水和海水等的一般性水質監測。近幾年研究發現。TC、FC在生態、流行程度和抵抗外界刺激等方面與其指示的很多病原微生物存在相當大的差異。隨著對檢測指示菌的靈敏度和準確性要求越來越高,為了更好地檢測水體中受糞便污染的情況,大腸埃希菌、腸球菌、產氣莢膜梭菌等具有更好指示能力、與污染水體病原微生物具有更加密切相關的指示微生物得到了廣泛套用 。
(4)大腸埃希菌
埃希里奇於1885年首先由分離到該菌,1893年西奧博爾德.史密斯指出,大腸埃希菌普遍存在於人類和動物的腸道內,在自然水體中不能長時間存活,所以若在環境中發現,就可以認為是被人和動物的糞便所污染。因鑑定複雜,以前使用不多。但近年來隨著測定新方法的建立。E.coli作為糞便污染的指示菌套用越來越多。如美國環境保護署2000年頒布的飲用水和娛樂用水TC和E.coli的檢測方法中,利用E.coli產生的葡萄糖普酸酶,分解吲哚葡萄糖酸苷,產生有色物質,而使E.coli菌落顯色,對E.coli'數進行測定(酶底物法)。我國2006年版的《生活飲用水衛生標準檢驗方法》也把該方法作為了標準檢驗方法。大腸埃希菌能較好指示腸道的病原微生物污染情況,是較好的糞便污染的指示菌,檢出的意義最大 。
(5)腸球菌
腸球菌原歸屬於鏈球菌屬的D血清群。腸球菌是人和溫血動物腸道內的正常菌群之一,在人和動物體內含量不同,主要棲居於動物腸道內的腸球菌數量較多,一般多於E.coli;而在人體內相對較少,在人糞中所占比例少於E.col了,每克糞便約含10的5次方個。一般根據兩者比值判斷污染來源。FC與腸球菌的比值大於4.1,可認為污染的來源為人體糞便;小於0.7,可認為污染的來源是動物糞便;介於兩者之間可認為是人和動物的糞便混合污染。腸球菌對冷、熱、鹼等惡劣環境抵抗力較強,對含氯消毒劑較TC更具耐受力,在富含營養的水體中繁殖力低於大腸菌群,這些更符合糞便指示菌的條件 。
(6)產氣莢膜梭菌
產氣莢膜梭菌是腸道正常菌群之一,是革蘭氏陽性、專性厭氧、有芽抱的腸道條件致病菌,其抱子在水體中的存活時間與有些寄生蟲如賈第鞭毛蟲屬和隱抱子蟲屬等的抱囊和卵囊在水體中存活的時間相當,所以可用來指示這些寄生蟲的污染。產氣莢膜梭菌還以較低的濃度存在於熱帶區的土壤與河流中,當有污水或糞便污染時,它們的數量就會大大增加,所以也可以用於檢測熱帶水體的污染。由於產氣莢膜梭菌的抱子對外界有很強的抵抗能力、在環境中能存活很長時間,故能較好地預示過去可能發生的污染。聯合使用大腸埃希菌和產氣莢膜梭菌可同時檢測溪水和湖泊等變化較小的水體環境中新近和過去可能發生的糞便污染 。

